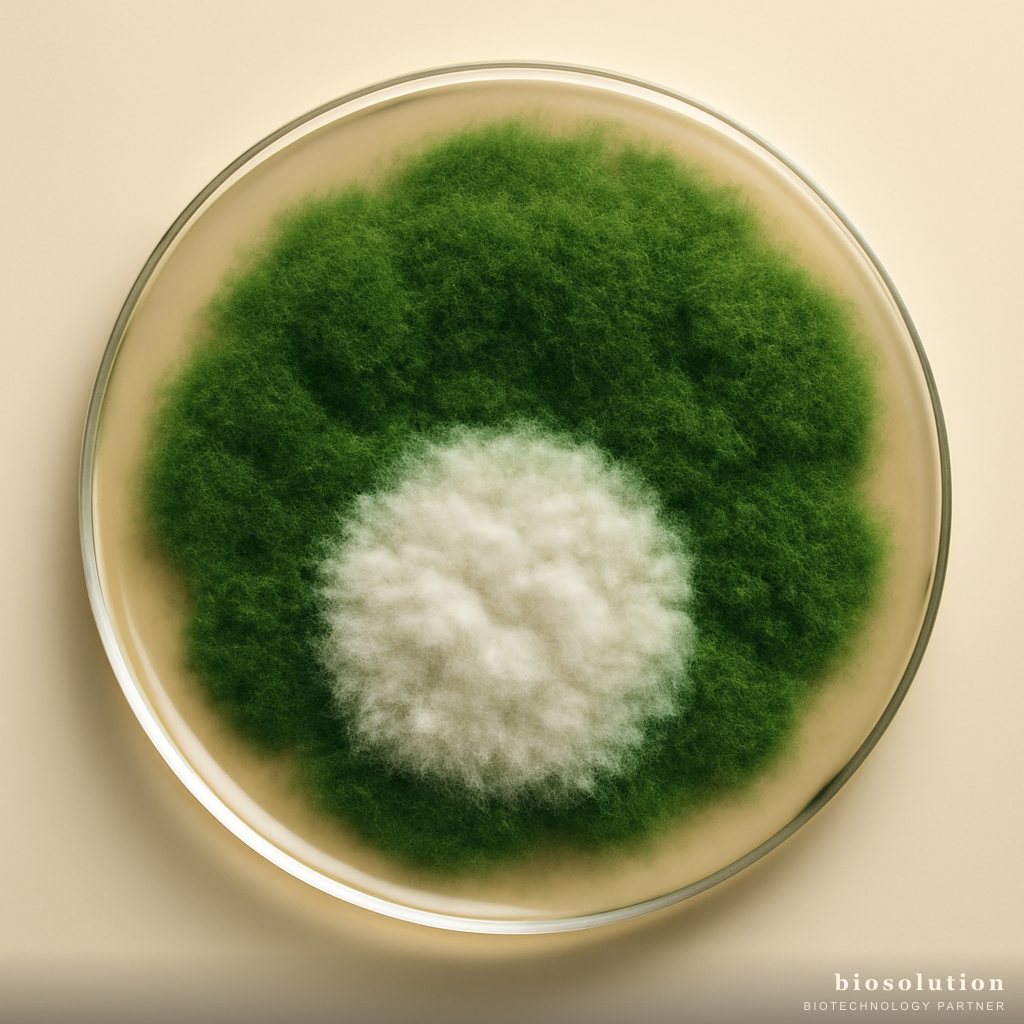
Biofungisida Trichoderma untuk Patogen Tular Tanah

Memuat...
Berita & Studi Kasus
Riset, studi kasus, dan panduan praktis bioteknologi.
Insight terkini untuk petani, peternak, dan pembudidaya Indonesia. 173 artikel dan terus bertambah.

Biocontrol
Anti Wereng Padi Alami: Kendalikan Wereng Coklat dan Hijau Tanpa Kimia
Wereng coklat dan hijau adalah hama utama padi yang dapat menyebabkan kehilangan hasil hingga 60%. Artikel ini membahas siklus hidup, gejala serangan, dan ambang ekonomi, serta solusi alami menggunakan Formula Anti-Wereng Padi berbasis Beauveria bassiana dan Metarhizium anisopliae.
Dr. Nurul Hasanah, M.Sc. 9 min

Biocontrol
Insektisida Hayati Spektrum Luas: Solusi Resistensi Hama
Resistensi hama terhadap pestisida kimia menjadi ancaman serius produktivitas pertanian. Insektisida hayati spektrum luas berbasis Beauveria bassiana dan Metarhizium anisopliae hadir sebagai solusi efektif dengan mekanisme kerja multi-target yang sulit ditembus resistensi. Artikel ini mengupas tuntas fenomena resistensi, keunggulan formula hayati, dan panduan aplikasi tepat guna.
Ir. Bambang Sutomo 9 min

Biocontrol
Anti Layu Fusarium Tomat: Panduan Lengkap Pengendalian
Layu Fusarium yang disebabkan oleh Fusarium oxysporum merupakan penyakit tular tanah yang paling merugikan pada tanaman tomat dan cabai. Artikel ini membahas siklus hidup patogen, gejala, ambang ekonomi, serta strategi pengendalian menggunakan agen hayati seperti Trichoderma harzianum, Gliocladium virens, dan Pseudomonas fluorescens yang dikemas dalam Formula Anti-Layu Fusarium dari Biosolution.
Ir. Bambang Sutomo 9 min

Biocontrol
Anti Ganoderma Sawit BSR: Biokontrol Busuk Pangkal
Penyakit busuk pangkal batang (BSR) akibat Ganoderma boninense adalah ancaman utama perkebunan sawit. Artikel ini mengulas siklus hidup patogen, gejala infeksi, ambang ekonomi, dan biokontrol menggunakan konsorsium Trichoderma harzianum, Gliocladium virens, dan Bacillus subtilis sebagai solusi anti ganoderma sawit BSR.
Dr. Aryo Wibowo 9 min

Biocontrol
Insektisida Hayati Spektrum Luas: 4 Formula Pengendalian Hama
Insektisida hayati spektrum luas dengan kombinasi Beauveria bassiana dan Metarhizium anisopliae menawarkan solusi efektif pengendalian hama tanpa residu. Artikel ini membahas dosis, timing aplikasi, dan tips kombinasi adjuvant untuk hasil maksimal.
Diah Savitri, S.P., M.Sc. 9 min

Biocontrol
Anti Wereng Padi Alami: Kendalikan Wereng Coklat dan Hijau Tanpa Kimia
Wereng coklat dan hijau menjadi ancaman utama produktivitas padi. Pengendalian kimia sering memicu resurjensi dan resistensi. Artikel ini mengupas strategi pengendalian hayati dengan Formula Anti-Wereng Padi yang mengandung Beauveria bassiana dan Metarhizium anisopliae. Simak cara aplikasi, mekanisme kerja, dan keunggulannya sebagai solusi anti wereng padi alami.
Diah Savitri, S.P., M.Sc. 8 min

Biocontrol
Anti Penggerek Kumbang Sawit Oryctes: Biokontrol dengan Metarhizium
Kumbang penggerek pucuk sawit (Oryctes rhinoceros) menjadi ancaman serius bagi perkebunan sawit. Artikel ini membahas strategi biokontrol menggunakan Formula Anti-Penggerek Kumbang Sawit berbasis Metarhizium anisopliae yang mampu menekan populasi hingga 70-80% secara alami.
Indah Permatasari, M.P. 9 min

Biocontrol
Anti Penggerek Buah Kopi CBB: Kendalikan Hama Kopi dengan Biologi
Hama penggerek buah kopi (CBB) yang disebabkan oleh Hypothenemus hampei semakin resisten terhadap pestisida kimia. Artikel ini mengupas mengapa pendekatan kimia gagal dan bagaimana formula biologi berbasis Beauveria bassiana dan Metarhizium anisopliae dari Biosolution menjadi solusi efektif untuk petani kopi spesialty.
Bagus Pamungkas, M.P. 10 min
Biocontrol
Biofungisida Trichoderma untuk Patogen Tular Tanah
Artikel ini mengulas strategi pengendalian hayati menggunakan biofungisida Trichoderma (Trichoderma harzianum dan Gliocladium virens) untuk mengatasi patogen tular tanah seperti Fusarium, Phytophthora, dan Sclerotium. Cocok untuk petani komersial yang ingin beralih ke pertanian berkelanjutan.
Dr. Nurul Hasanah, M.Sc. 10 min

Biocontrol
Anti Kutu Daun Aphid Kebul: Biokontrol Kutu Daun dan Kutu Kebul
Artikel ini membahas biokontrol kutu daun (aphid) dan kutu kebul (whitefly) secara ilmiah. Pelajari siklus hidup, gejala serangan, ambang ekonomi, serta peran agens hayati seperti Verticillium lecani dan Cordyceps spp. dalam pengendalian ramah lingkungan.
Siti Rahayu, S.P. 9 min

Biocontrol
Anti Lalat Buah Bactrocera: Kendalikan Hama pada Mangga dan Jambu
Lalat buah Bactrocera merupakan hama utama pada tanaman mangga dan jambu yang menyebabkan kerugian besar. Artikel ini mengupas tuntas siklus hidup, gejala serangan, ambang ekonomi, serta cara pengendalian ramah lingkungan menggunakan Formula Anti-Lalat Buah dari Biosolution berbasis Metarhizium anisopliae.
Andi Prakoso S.P. 8 min

Biocontrol
Anti Wereng Padi Alami: 3 Formula Ampuh Kendalikan Wereng Coklat & Hijau
Wereng coklat dan hijau semakin resisten terhadap pestisida kimia. Temukan 3 formula anti wereng padi alami berbasis jamur entomopatogen Beauveria bassiana dan Metarhizium anisopliae yang ampuh, aman bagi predator alami, dan tidak menyebabkan resurjensi.
Andi Prakoso S.P. 10 min